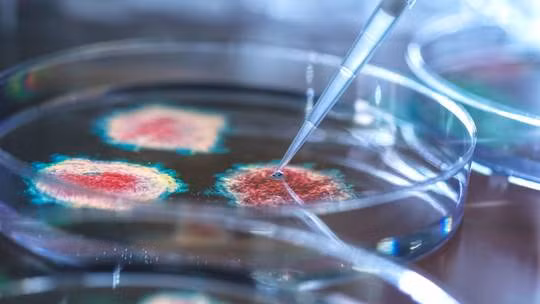
Nga lo Mỹ đang thực hiện các âm mưu gây mối họa sinh học ở Ukraine. Ảnh minh họa: RT

Trang RT hôm 8/4 dẫn thông báo từ Chỉ huy Lực lượng Phòng thủ Hạt nhân, Sinh học và Hóa học của Nga (trực thuộc Bộ Quốc phòng Nga), Trung tướng Igor Kirillov cho hay, Mỹ đang âm thầm nối lại chương trình phòng thí nghiệm sinh học gây tranh cãi tại Ukraine.
Trong cuộc họp báo, ông Kirillov còn đã trình bày các tài liệu về chương trình sinh học mà phía Nga tin rằng do Mỹ tài trợ ở Ukraine. Phía Mỹ bị cho là đang tập trung vào việc xây dựng các cơ sở bí mật mới cũng như đào tạo nhân sự.
Trung tướng Kirillov đã trích dẫn thông tin mà phía Nga nắm được từ một cuộc họp ngày 20/10/2022, với sự tham dự của đại diện Cơ quan Giảm thiểu Đe dọa Quốc phòng Mỹ (DTRA) và nhiều quan chức Ukraine và Công ty kỹ thuật Jacobs/CH2M, tập trung vào việc nối lại nghiên cứu sinh học ở Ukraine, vốn đã bị “tạm dừng” do sự thù địch giữa Moscow và Kiev.
“Giờ đây, dự án đã được nối lại với trọng tâm là đổi mới hỗ trợ pháp lý, sửa đổi lịch trình đào tạo, cũng như nối lại và kết thúc công việc xây dựng” - một nghị định thư bằng tiếng Ukraine trích lời đại diện David Smith của Jacobs/CH2M nêu rõ.
Tài liệu chỉ ra rằng chương trình này trước đây được gọi là 'Nghiên cứu sinh học chung' nhưng đã được đổi tên thành 'Nghiên cứu kiểm soát sinh học', bao gồm những lo ngại về một "chiến dịch thông tin sai lệch của Nga" về vấn đề này.
Trung tướng Nga Kirillov khẳng định, theo nghị định thư tại cuộc họp trên, phía chính quyền Mỹ đã tham gia vào các nỗ lực kiểm soát thiệt hại để ngăn chặn khả năng rò rỉ thông tin từ các chuyên gia Ukraine về bản chất thực sự của các chương trình nghiên cứu sinh học.
Cũng theo ông, một số người tham gia chương trình đã trốn khỏi lãnh thổ Ukraine và phía Mỹ đang tích cực thực hiện các biện pháp khẩn cấp để truy lùng cũng như lấy lại các thông tin liên quan đến những thí nghiệm sinh học đã hoàn thành.
Một tài liệu khác cho rằng việc kiểm soát thiệt hại của Mỹ đối với các thành viên tham gia chương trình đã được thực hiện ngay sau khi xung đột giữa Nga và Ukraine bùng nổ hồi tháng 2/2022.
Một bản ghi nhớ dự thảo có tiêu đề "Giảm thiểu mối đe dọa phổ biến chuyên môn của Ukraine đối với các đối thủ của Mỹ" do Laura Denlinger, cố vấn cấp cao về chống phổ biến vũ khí hạt nhân của Bộ Ngoại giao Mỹ chắp bút.
Bản ghi nhớ ngày 11/3/2022 viết: “Cuộc xâm lược của Nga vào Ukraine đã dẫn đến cuộc di cư của các chuyên gia kỹ thuật có năng lực cao khỏi các cơ sở Ukraine sản xuất các bộ phận tên lửa và vũ khí thông thường tiên tiến (ACW), cũng như những người có chuyên môn có thể bị người khác chuyển hướng và khai thác cho một chất hóa học, vũ khí sinh học, phóng xạ hoặc hạt nhân (CBRN)".
Trong các báo cáo với truyền thông trước đó, Bộ Quốc phòng Nga đã cáo buộc phía Mỹ yêu cầu các phòng thí nghiệm tại Ukraine tham gia vào chương trình chống lại mầm bệnh đặc biệt nguy hiểm nhưng được triển khai bằng cách gửi các mẫu mầm bệnh cho phía Ukraine một cách không theo các quy chuẩn có kiểm soát.
Cụ thể, phía công ty Jacobs/CH2M - một nhà thầu của Bộ Quốc phòng Mỹ và các phòng nghiên cứu sinh học tại Ukraine đã trao đổi các thông tin liên quan đến việc vận chuyển bằng đường hàng không các mẫu mầm bệnh nguy hiểm.
Vào tháng 1 năm 2023, chính phủ Ukraine đã công bố một loạt các yêu cầu mới đối với việc “kế toán, lưu trữ, vận chuyển và tiêu hủy” các mầm bệnh khác nhau, trong đó bao gồm hướng dẫn vận chuyển quốc tế bằng đường hàng không các chất có mức độ nguy hiểm cao nhất.
Các mẫu vật liệu sinh học nguy hiểm này được gửi qua lại đến địa chỉ các phòng thí nghiệm của Mỹ.
Cơ quan Giảm thiểu Đe dọa Quốc phòng Mỹ (DTRA) cũng vạch ra các nhiệm vụ trong tương lai của phía Ukraine như "củng cố các bộ sưu tập mầm bệnh nguy hiểm và triển khai các hệ thống quản lý rủi ro sinh học và theo dõi tình hình dịch tễ học".
Trung tướng Nga Kirillov cảnh báo rằng Kiev và Washington có khả năng sử dụng nghiên cứu của họ để thực hiện “các hành động khiêu khích với mầm bệnh nguy hiểm”, mà sau này họ sẽ đổ lỗi cho Nga.
Theo quan chức Bộ Quốc phòng Nga, công việc của các phòng thí nghiệm sinh học Mỹ đối với mầm bệnh nguy hiểm có thể ví là "đỉnh cao của sự liều lĩnh” trong bối cảnh bùng phát virus như bệnh than và dịch tả ở nhiều nơi trên thế giới và sự gia tăng các bệnh ở động vật như dịch tả lợn châu Phi, dịch cúm gia cầm, lở mồm long móng.
Đặc biệt, ông Kirillov cũng chỉ trích ngành dược phẩm Mỹ đang hướng tới lợi nhuận không giới hạn như cách Giám đốc nghiên cứu R&D của Pfizer Jordan Walker thừa nhận rằng, đang tiến hành nghiên cứu “tiến hóa có định hướng” đối với virus Covid-19, nhằm “chủ động phát triển vaccine mới".
 |
| Chỉ huy Lực lượng Phòng thủ Hạt nhân, Sinh học và Hóa học của Nga, Trung tướng Igor Kirillov. |
Từ khi triển khai chiến dịch quân sự đặc biệt, quân đội Nga đã thu được hơn 20.000 tài liệu liên quan đến các chương trình nghiên cứu sinh học của Mỹ ở Ukraine.
Theo đó, những người có liên quan đến chương trình này gồm một số đại diện của Đảng Dân chủ Mỹ, các quan chức Bộ Quốc phòng và nhà thầu của Lầu Năm Góc.
Phía Nga hồi tháng 1/2023 còn nêu ra hàng loạt cái tên khác như Karen Saylors, giám đốc điều hành của Labyrinth Global Health, người được cho là đã làm việc tại Ukraine với tư cách là cố vấn chính cho một dự án nghiên cứu sự lây lan của dịch tả lợn châu Phi.
Người khác là Colin Johnson, một nghiên cứu sinh tại Đại học Tennessee và là Giám đốc của Viện Hệ thống mầm bệnh vật chủ, người được cho là đã nghiên cứu về bệnh sốt Crimean-Congo và Hội chứng Hanta Virus ở Ukraine và chịu trách nhiệm thu thập các mẫu sinh học từ các quân nhân Ukraine.
Chỉ huy Lực lượng Phòng thủ Hạt nhân, Sinh học và Hóa học của Nga Igor Kirillov cũng nhắc lại quan điểm của Nga rằng mục tiêu chính của các chương trình sinh học của Mỹ trên toàn thế giới là “thiết lập kiểm soát sinh học toàn cầu” bằng cách làm suy giảm hệ thống y tế quốc gia của các quốc gia khác và phá vỡ các điều khoản của Công ước Vũ khí Sinh học và Chất độc (BTWC) bằng chính các quy tắc được phát triển để phục vụ lợi ích của Washington và các đồng minh.
Nga đã đệ trình dữ liệu về các phòng thí nghiệm bất hợp pháp do Mỹ hậu thuẫn ở Ukraine cho Tổ chức Cấm Vũ khí Hóa học.
Theo Bộ Quốc phòng Nga, dữ liệu đó bao gồm bằng chứng tài liệu hoạt động với các bộ phận của vũ khí sinh học và các nghiên cứu về mầm bệnh đặc biệt nguy hiểm đã được thực hiện ở Ukraine với sự hỗ trợ về tài chính, khoa học, kỹ thuật và nhân sự của Mỹ. Washington đã bác bỏ cáo buộc của Moscow, gọi đó là thông tin sai lệch.
Moscow cũng đã đưa vấn đề phòng thí nghiệm sinh học lên Liên Hợp Quốc vào tháng 10 năm ngoái, yêu cầu một cuộc điều tra quốc tế. Tuy nhiên, đề nghị này đã bị Hội đồng Bảo an Liên Hợp Quốc bác bỏ, với Mỹ, Anh và Pháp bỏ phiếu chống.